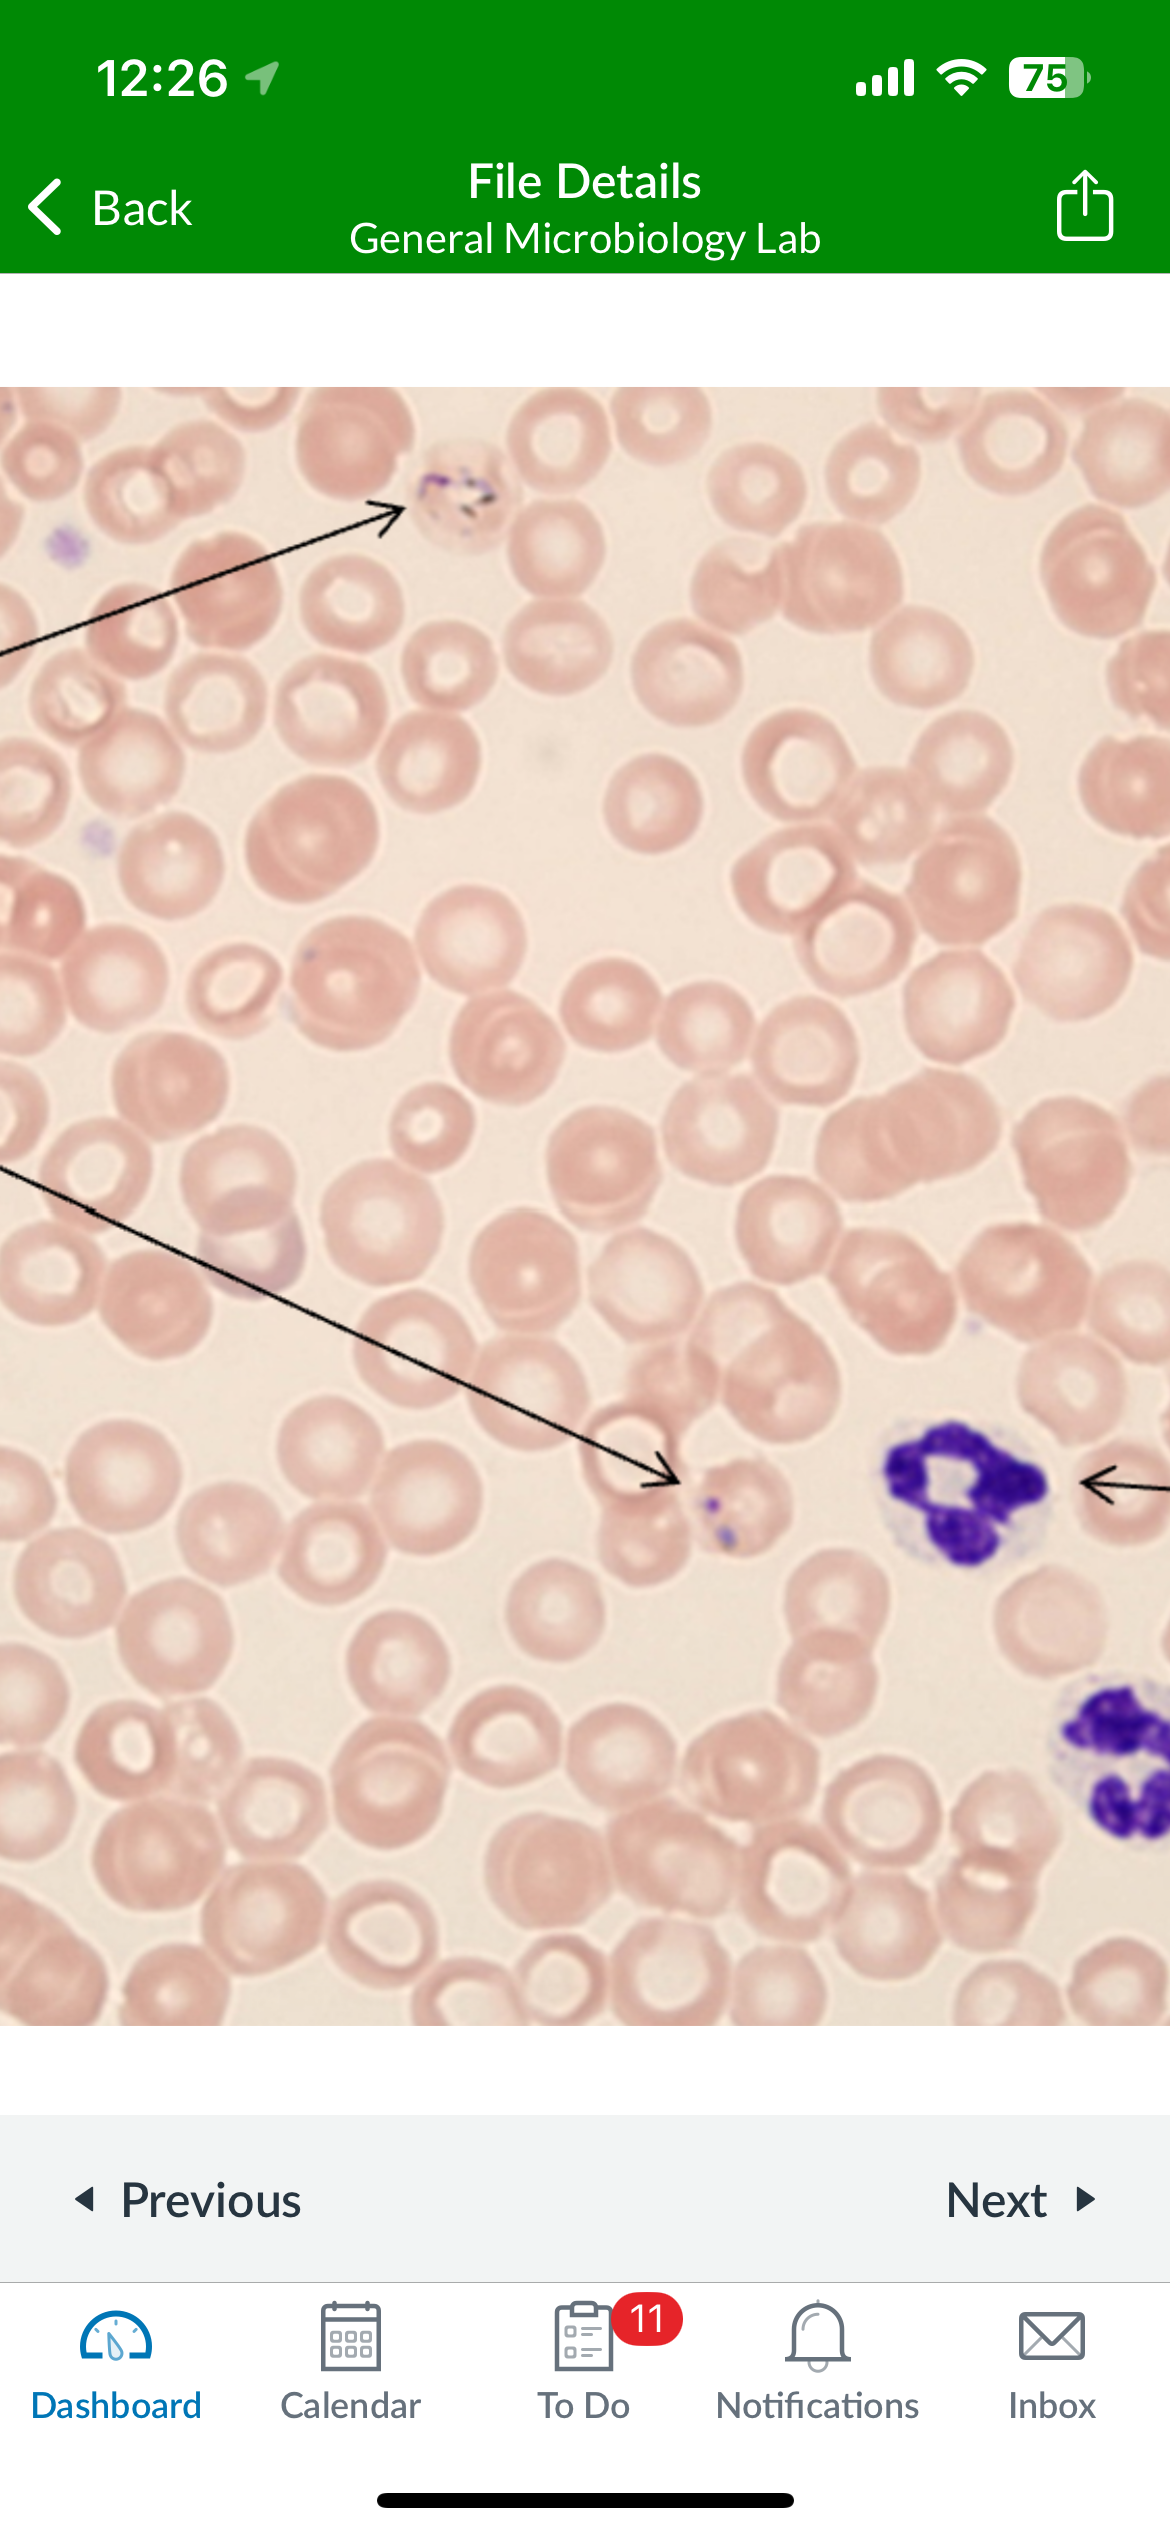
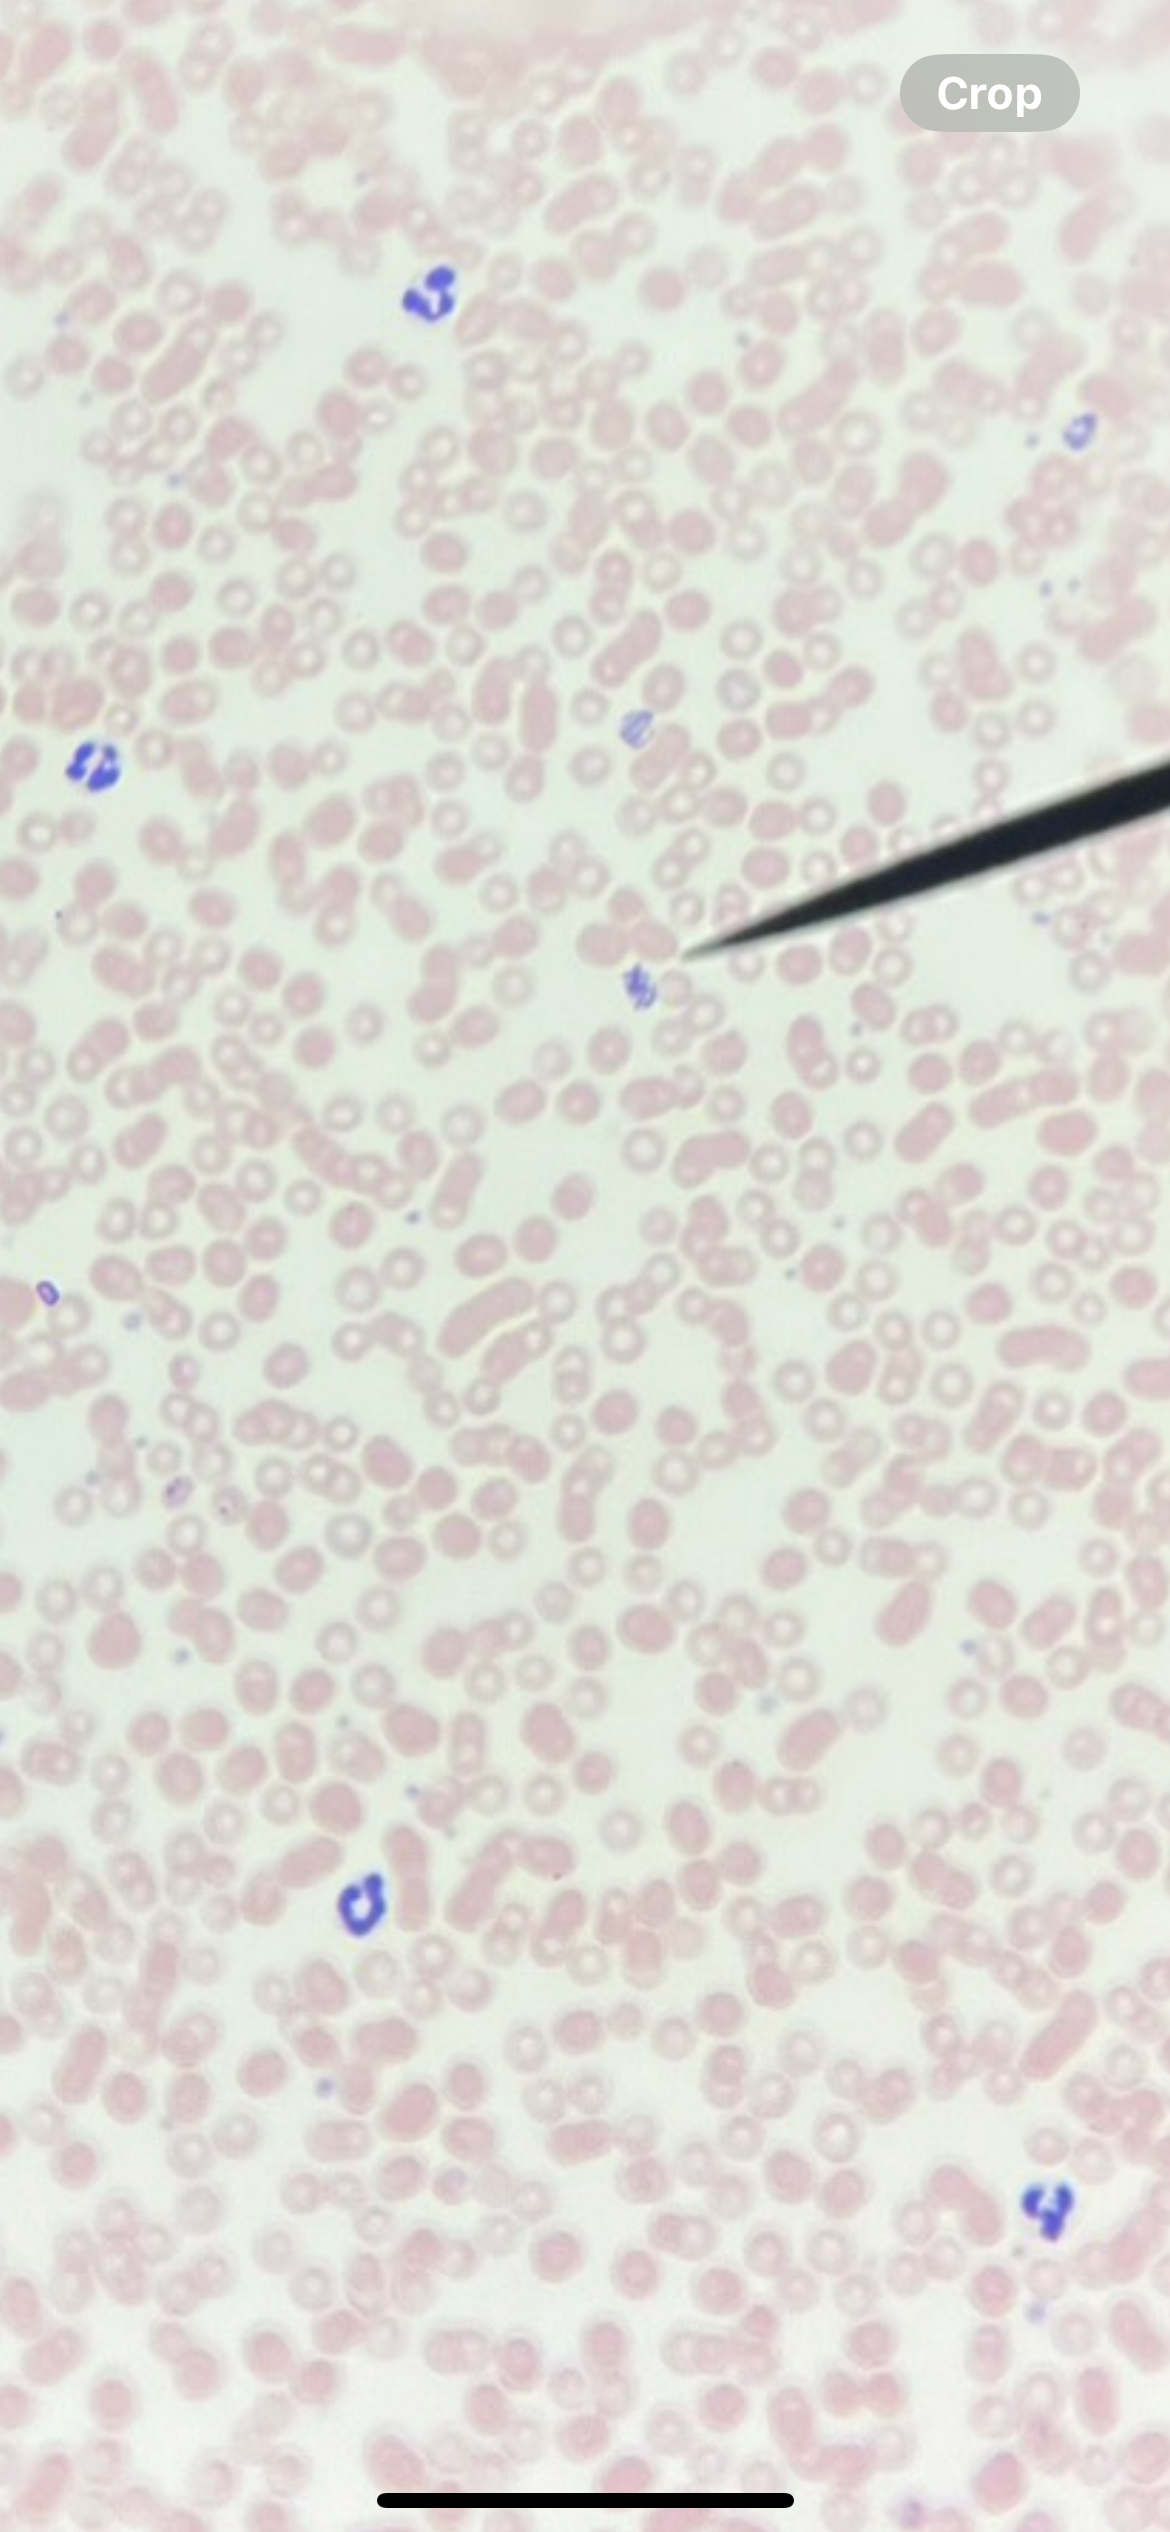

eukaryotic identification
0.0(0)
Card Sorting
1/20
There's no tags or description
Looks like no tags are added yet.
Study Analytics
Name | Mastery | Learn | Test | Matching | Spaced |
|---|
No study sessions yet.
21 Terms
1
New cards

Rhizopus
2
New cards

Penicillium
3
New cards

Aspergillus
4
New cards
5
New cards

Histoplasma capsulatum
6
New cards

Candida albicans
7
New cards

Candida albicans
8
New cards

Saccharomyces crisis
9
New cards

Amanita phalloides
10
New cards

Amanita phalloides
11
New cards

Balantidium coli
12
New cards

Naegleria Fowler
13
New cards

Trichomonas vaginalis
14
New cards

Entamoeba histolytica
15
New cards
Plasmodium malariae
16
New cards

Saccharomyces cerevisiae
17
New cards

Rhizopus
18
New cards

Aspergillus
19
New cards

Penicillium
20
New cards
Plasmodium malariae
21
New cards

Giardia lamblia